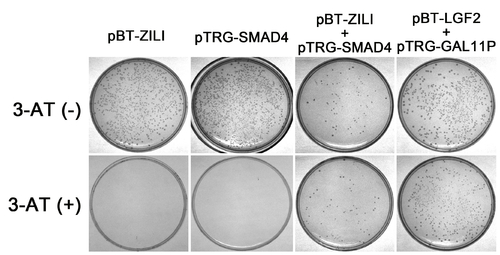

Fig. S7
|
Validation of interaction between Zili and Smad4 by Two-Hybrid experiment in Bacterial system. The BacterioMatch II two-hybrid system detects protein-protein interactions based on transcriptional activation of the HIS3 reporter gene, which allows growth in the presence of 3-amino-1,2,4-triazole (3-AT), a competitive inhibitor of His3 enzyme. Both pBT-Zili and pTRG-Smad4 can not produce a significant number of colonies on Selective Screening Medium (5 mM 3-AT) alone, suggesting that they are suitable for use in this system. And significant growth on 5 mM 3-AT is observed in cotransformation experiment of pBT-Zili and pTRG-Smad4, similar to the pTRG-Gal11P and the pBT-LGF2 positive control plasmids, indicating an interaction. |